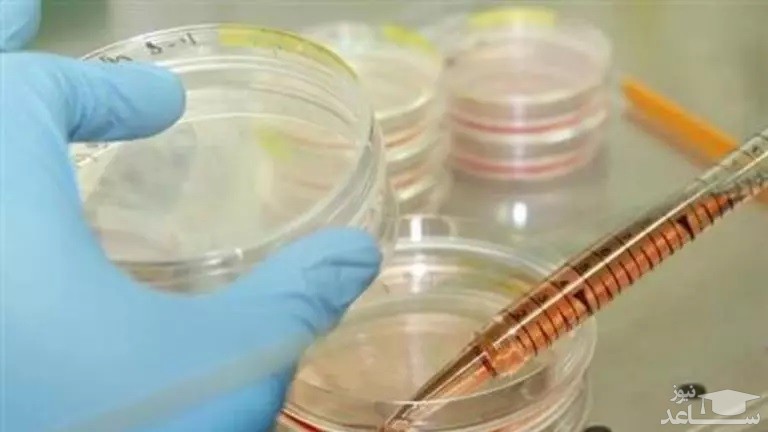
تصویر

به گزارش پایگاه خبری-تحلیلی ساعدنیوز به نقل از برترین ها، در مطالعه ای جدید، دانشمندان موفق شدند سلول های مغزی خوک های مرده را یک ساعت پس از مرگ آن ها زنده کنند. این فرآیند بازگشت از مرگ دریچه ای نوین به روی دنیای علم و پیشرفت باز کرده است که می تواند منجر به کشف روش هایی برای بازگرداندن مردگان به زندگی شود. در همین ارتباط، وبسایت گجت نیوز در گزارشی به ابعاد بزرگتر این مساله می پردازد.

آنچه پس از این پمپاژ اتفاق افتاد، قطعا سؤالاتی درباره ی شکاف بین مرگ و زندگی و بازگشت از مرگ را از دیدگاه علمی در ذهن ها ایجاد می کند. اگرچه خوک ها در آن وضعیت به هیچ وجه هوشیار در نظر گرفته نمی شدند، اما سلول های به ظاهر مرده آن ها دوباره زنده شدند. قلب آن ها پس از تزریق محلول ویژه که دانشمندان آن را OrganEx نامیدند، شروع به تپیدن کرد و خون در رگ ها و شریان ها به گردش در آمد.
سلول های اندام های خوک ها، از جمله قلب، کبد، کلیه ها و مغز، دوباره کار می کردند و حیوانات هرگز مانند یک خوک مرده معمولی سفت نشدند. سایر خوک ها که به مدت یک ساعت مرده بودند، تحت درمان با دستگاهی به نام ECMO قرار گرفتند، دستگاهی که خون را در بدن آن ها پمپاژ می کرد. پس از متصل شدن خوک ها به این دستگاه، آن ها سفت شدند، اندام هایشان متورم شد و آسیب دید، رگ های خونی شان پاره شد و لکه های ارغوانی رنگ در قسمت پشت بدنشان که خون جمع در آنجا جمع می شد، قابل مشاهده بود.
این گروه از محققین، نتایج مطالعات خود را در مورد نحوه بازگشت از مرگ برای خوک ها، روز چهارشنبه در مجله منتشر کردند. محققان می گویند هدف آن ها این است که روزی با اجازه دادن به پزشکان برای به دست آوردن اندام های زنده پس از مرگ، عرضه اندام های انسانی را برای پیوند افزایش دهند و آرزوی دیرینه انسان را در مورد بازگشت از مرگ به واقعیت تبدیل کنند. آن ها همچنین امیدوارند که فناوری مورد استفاده در این تحقیق برای جلوگیری از آسیب شدید به قلب پس از حمله قلبی ویرانگر، یا آسیب وارده به مغز پس از یک سکته مغزی استفاده شود.

سرپرست این گروه تحقیقاتی، دکتر نناد سستان، استاد اعصاب، ژنتیک و روانپزشکی در دانشکده پزشکی ییل است. تمامی آن ها از توانایی خارق العاده OrganEx در احیای سلول های مرده شگفت زده شدند. دکتر دیوید آندریوویچ، متخصص علوم اعصاب در دانشگاه ییل و یکی از نویسندگان مقاله، می گوید: «ما نمی دانستیم چه انتظاری داشته باشیم. هر چیزی که ما بازسازی کردیم برای ما باورنکردنی بود.»
سایر محققین که در این آزمایش حضور نداشتند نیز به همین ترتیب از موفقیت این آزمایش شگفت زده شدند. نیتا فراهانی، استاد حقوق دوک که پیامدهای اخلاقی، حقوقی و اجتماعی فناوری های نوظهور را مطالعه می کند، می گوید: «این یک رویداد باورنکردنی و شگفت انگیز است. این آزمایش سوالات بسیاری را در مورد تعریف مرگ و امکان بازگشت از مرگ ایجاد کرده است. ما فرض می کنیم که مرگ یک پدیده و یک حالت وجودی است. ولی حال سوال اینجاست که آیا امکان بازگشت از مرگ واقعا وجود دارد یا خیر؟»
این پروژه چندین سال پیش در زمانی آغاز شد که گروه محققان دانشگاه ییل آمریکا آزمایش مشابهی را با مغز خوک های مرده از یک کشتارگاه انجام دادند. چهار ساعت پس از مرگ خوک ها، گروه محلولی شبیه به OrganEx را که BrainEx نام داشت به خوک ها تزریق کردند و دیدند که سلول های مغزی که در حالت طبیعی باید مرده باشند می توانند احیا شوند. دکتر زوانمیر ورسلیا، یکی دیگر از اعضای تیم دانشگاه ییل، می گوید که همین موضوع سبب شد آن ها از خود بپرسند که آیا می توانند تمامی اعضای بدن را احیا کنند؟
ویژگی های محلول OrganEx
هنگامی که دانشمندان خوک های مرده را احیا کردند، اقدامات احتیاطی را انجام دادند تا مطمئن شوند که حیوانات دردی را حس نخواهند کرد. خوک ها قبل از کشته شدن با توقف قلبشان بیهوش شدند و این بیهوشی عمیق در طول آزمایش ادامه یافت. بعلاوه، مسدود کننده های عصبی موجود در محلول OrganEx از فعالیت سلول های عصبی جلوگیری می کردند تا از فعال نبودن مغز اطمینان حاصل شود.
محققان همچنین بدن حیوانات را سرد کردند تا سرعت واکنش های شیمیایی را کاهش دهند. تک تک سلول های مغز زنده بودند، اما هیچ نشانه ای از فعالیت عصبی سازمان یافته در مغز وجود نداشت.
تکان دادن سر توسط خوک های مرده
در این آزمایش یک یافته شگفت انگیز وجود داشت: خوک هایی که تحت درمان با OrganEx قرار گرفتند، زمانی که محققان محلول کنتراست ید را برای تصویربرداری تزریق کردند، سر خود را تکان دادند. دکتر لاتام تاکید کرد که در حالی که دلیل این حرکت مشخص نیست، هیچ نشانه ای از درگیری مغز وجود ندارد.

ژورنال نیچر از دو متخصص مستقل خواست تا نظرات خود را در مورد این مطالعه بنویسند. اولین متخصص، دکتر رابرت پورت، جراح پیوند در دانشگاه گرونینگن در هلند، در مورد استفاده احتمالی از این فناوری جدید برای گسترش مجموعه اعضای موجود برای پیوند بحث کرد. در یک مصاحبه تلفنی، او توضیح داد که OrganEx ممکن است در آینده در شرایطی استفاده شود که در آن بیماران مرگ مغزی نداشته باشند، اما آسیب مغزی دارند تا حدی که امکان بازگشت از مرگ برای آن ها به صورت طبیعی وجود ندارد.
دکتر پورت همچنین ادامه داد که در اکثر کشورها، به مدت پنج دقیقه پس از خاموش شدن دستگاه تنفس مصنوعی و قبل از برداشته شدن اعضا توسط جراح، هیچ کس اجازه ندارد به فردی که جان خود را از دست داده دست بزند. دکتر پورت گفت: «قبل از رساندن فرد به اتاق عمل زمان بیشتری سپری می شود و پس از گذر این زمان ممکن است اعضای داخلی به حدی آسیب دیده باشند که دیگر قابل استفاده نباشند.»
گاهی اوقات بیماران بلافاصله پس از قطع دستگاه نمی میرند، اما قلب آن ها بسیار ضعیف می تپد تا اندام هایشان سالم بمانند. دکتر پورت گفت: «در بیشتر کشورها، تیم های پیوند دو ساعت منتظر می مانند تا از مرگ کامل بیمار مطمئن شوند و سپس فوت او را گزارش دهند. اگر پس از گذشت این زمان بیمار هنوز زنده باشد، دکترها برای بازیابی اعضای بدن اقدام نمی کنند.» در نتیجه، ۵۰ تا ۶۰ درصد بیمارانی که پس از قطع دستگاه تنفس مصنوعی و سایر دستگاه ها جان خود را از دست دادند و خانواده هایشان خواستار اهدای اعضای بدن خود بودند، نمی توانستند اهداکننده باشند.

نظر دیگر توسط برندان والد، وکیل و متخصص اخلاق که مدیر اخلاق پیوند و تحقیقات سیاستی در دانشکده پزشکی گروسمن دانشگاه نیویورک است، به ژورنال نیچر داده شد. در یک مصاحبه تلفنی، او در مورد سوالات پیچیده ای درباره زندگی و مرگ که OrganEx مطرح می کند، صحبت کرد.
آقای والد گفت: «طبق تعریف قانونی و پزشکی پذیرفته شده از مرگ، این خوک ها مرده بودند. اما یک سوال مهم وجود دارد و آن این است که چه کارکردی و چه نوع عملکردی توان تغییر این شرایط را داشت؟ آیا اگر این گروه از مسدود کننده های عصبی در محلول خود استفاده نمی کردند و مغز آن ها دوباره کار می کرد، خوک ها دیگر امکان بازگشت از مرگ را نداشتند؟»
اگر هدف اصلی این پژوهش حفظ اعضای بدن برای پیوند باشد و خوک ها در طول این فرآیند تا حدودی هوشیاری خود را به دست آورند، آنوقت این موضوع مشکلات اخلاقی ایجاد می کند. اما اگر بیمار دچار سکته مغزی شدید یا قربانی غرق شدگی شده باشد، بازیابی عملکرد مغز می تواند به عنوان هدف اصلی معرفی شود. آقای والد در این باره گفت: «اگر می خواهیم این فناوری را به نقطه ای برسانیم که بتواند به جامعه انسانی کمک کند، باید ببینیم بدون مسدودکننده های عصبی در مغز چه اتفاقی می افتد.»
به نظر او، این روش در نهایت باید بر روی افرادی آزمایش شود که می توانند از آن سود ببرند، مانند قربانیان سکته مغزی یا غرق شدگان. اما این امر به سادگی قابل انجام نیست و مستلزم تامل زیادی توسط متخصصان اخلاق و عصب شناسان است. آقای والد گفت: «اینکه چگونه می توانیم به آنجا برسیم و چه زمانی داده هایی که ما داریم این جهش را توجیه می کند، سوالات بسیار مهمی هستند.»
موضوع دیگر پیامدهایی است که OrganEx ممکن است برای تعریف مرگ داشته باشد. اگر OrganEx نشان دهد که مدت زمان برگشت از مرگ سلول ها پس از محرومیت از خون و اکسیژن بسیار بیشتر از آن چیزی است که قبلاً تصور می شد، پس باید تغییری در مشخص کردن زمان مرگ افراد ایجاد شود. والد در این مورد اظهار نظر کرد: «این موضوع عجیب است، اما تفاوتی با آن چیزی که ما در ساخت دستگاه تنفس مصنوعی تجربه کردیم ندارد. جمعیت کاملی از مردم وجود دارند که ممکن است در دوره ای دیگر مرده محسوب شوند.»
ازدواج عجیب اما عاشقانه یک زن با مردی که فک و چانه ندارد










































